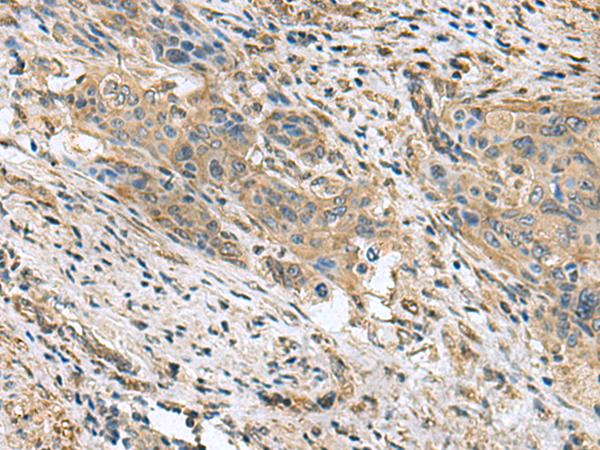
一抗

中文名稱: 兔抗PAPSS2多克隆抗體
英文名稱: Anti-PAPSS2 rabbit polyclonal antibody
別 名: 3'-phosphoadenosine 5'-phosphosulfate synthase 2; SK2; BCYM4; ATPSK2
相關(guān)類別: 一抗
儲 存: 冷凍(-20℃)
宿 主: Rabbit
抗 原: PAPSS2
反應(yīng)種屬: Human, Mouse
標(biāo) 記 物: Unconjugate
克隆類型: rabbit polyclonal
技術(shù)規(guī)格
|
Background: |
Sulfation is a common modification of endogenous (lipids, proteins, and carbohydrates) and exogenous (xenobiotics and drugs) compounds. In mammals, the sulfate source is 3'-phosphoadenosine 5'-phosphosulfate (PAPS), created from ATP and inorganic sulfate. Two different tissue isoforms encoded by different genes synthesize PAPS. This gene encodes one of the two PAPS synthetases. Defects in this gene cause the Pakistani type of spondyloepimetaphyseal dysplasia. Two alternatively spliced transcript variants that encode different isoforms have been described for this gene. |
|
Applications: |
ELISA, IHC |
|
Name of antibody: |
PAPSS2 |
|
Immunogen: |
Fusion protein of human PAPSS2 |
|
Full name: |
3'-phosphoadenosine 5'-phosphosulfate synthase 2 |
|
Synonyms: |
SK2; BCYM4; ATPSK2 |
|
SwissProt: |
O95340 |
|
ELISA Recommended dilution: |
5000-10000 |
|
IHC positive control: |
Human liver cancer and Human cervical cancer |
|
IHC Recommend dilution: |
50-300 |


 購物車
購物車 幫助
幫助
 021-54845833/15800441009
021-54845833/15800441009